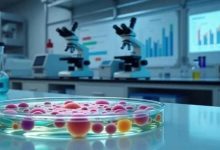
母子俩联手干出一个IPO，今年0营收，去年也才26万-程序员中文网

李国庆再婚迎娶“女同学”,俞渝接手股权独掌当当网
一别两宽、各生欢喜 作者 | 林玉麒 编辑丨高岩 来源 | 野马财经 8月16日,北京紫云轩酒店,61岁的当当网创始人李国庆紧握新娘张丹红的手,背景板上“依然相信爱情”的主题词格外醒目。李国庆迎来了人生中的又一重要时刻——婚礼。 据现场流出...

一别两宽、各生欢喜 作者 | 林玉麒 编辑丨高岩 来源 | 野马财经 8月16日,北京紫云轩酒店,61岁的当当网创始人李国庆紧握新娘张丹红的手,背景板上“依然相信爱情”的主题词格外醒目。李国庆迎来了人生中的又一重要时刻——婚礼。 据现场流出...

“撒钱”撒出了千亿市值。 8月18日,影石创新连续2个交易日20cm涨停,报269.3元,续创历史新高,市值达1080亿。 市场关注这家公司在8月15日,一段影石创新创始人刘靖康给员工撒钱的视频在网络上流传,迅速引发热议。 简单粗暴“撒钱”...

作者 | 第一财经 武子晔 近期,全国多个地方调整了汽车以旧换新政策。 8月17日,湖北省武汉市、襄阳市发布了关于调整2025年汽车以旧换新政策的公告,汽车置换更新政策自2025年8月19日24时起暂停实施,8月19日前购车的消费者需在8月...

8月18日,A股延续上行趋势,一片涨声中创出纪录——A股市值总和(A股最新价×A股总股本,下同)首次突破100万亿元大关。 截至当天收盘,上证指数报收3728.03点,涨0.85%,创10年新高;深成指报收11835.57点,涨1.73%;...

一场围绕“贷款炒股”的“金融攻防战”正在上演。 近期,随着A股市场活跃度提升,股指频创新高,银行紧急“封堵”信贷资金违规进入股市通道。8月以来,超十家银行密集发布公告,明确禁止信用卡资金用于炒股、虚拟币等投资领域,并升级贷前审核与贷后监控手...

作者 | 闰然 编辑 | 江江 新媒体编辑 | 宝珠 视觉 | 诺言 “老板撒钱”这事儿,看上去像是场大型行为艺术。这种充满视觉冲击力的激励方式,与企业创始人的个人特质一脉相承。 但比起撒钱的姿势,我们更该盯的是——钱从哪来,是从员工工资里...

“过七夕的钱已到手,感谢大A!”00后大胆入市,老股民却迟疑08-18 16:490评 Source link
8月15日,华芢生物科技(青岛)股份有限公司再次向香港联交所递表,计划在主板IPO。 招股书显示,华芢生物科技是一家生物制药公司,主攻方向是发现、开发和商业化伤口愈合的疗法,目前为血小板衍生生长因子(「PDGF」)药物,主要包含两款核心产品...

打爆空头,A股冲破100万亿市值了,沪指创十年新高。就这短短半个月时间,沪指从3400点,迅速突破3700点。按这节奏,站上4000点也近在眼前了。全市上涨超过4200只股票,开盘40分钟,成交就突破了一万亿。这一次,空头是真的被打爆了。 ...

今天,A股市场三大指数收涨,创业板指表现较为强势,全市场超4000只个股上涨。上证指数创近十年新高,深证成指、创业板指均突破2024年10月8日高点。午后,指数涨幅均有所收窄,市场热点快速轮动,PEEK、军工、数字货币板块活跃。 截至收盘,...